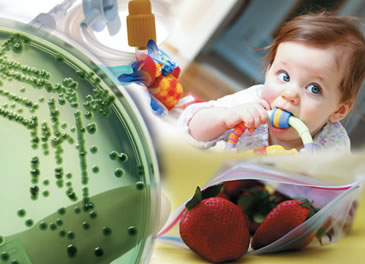
BACTFIX | Bactericida

Home / Aditivos
Com uma lista de mais de dez aditivos, a Colorfix criou a Linha Aditivos FIX. Além do ótimo custo-benefício, o investimento da companhia em nova tecnologia e adequação de fórmula reflete em maior qualidade para processo de transformação do cliente.
-
BACTFIX | Bactericida
A incorporação deste aditivo à matriz polimérica impede que fungos e bactérias se fixem ao substrato e se proliferem, evitando o aparecimento de manchas, odores e até perda de propriedades mecânicas.
-

BLOCKFIX | Antibloqueio
Este aditivo interage na superfície do material, criando microrugosidades que possibilitam a passagem de ar entre películas, diminuindo a área de contato e evitando sua aderência.
-

CLEARFIX | Clarificante
É um aditivo que quando adicionado aos polímeros semicristalinos, especificamente o PP, aumenta a transparência.
-

DESMOLFIX | Desmoldante
Facilita a extração de peças no processo de injeção, eliminando o tempo de parada de ciclo para retirada manual e danos às peças presas ao molde. Também pode ser utilizado nos processos de compressão, rotomoldagem e sopro.
-

DIFUSOR DE LUZ
Aditivo que adicionado ao processo torna o produto final capaz de difundir a luz de forma regular e uniforme.
-

EXOFIX | Expansor
Utilizado na redução de densidade e, consequentemente, peso da peça. Devido a transformação de estruturas celulares, também promove modificação da textura/acabamento, além de atuar nas propriedades mecânicas, térmicas e acústicas.
-

FLAMEFIX | Retardante à Chama
Reduz ou retarda a propagação da chama por meio da massa ou da superfície dos materiais poliméricos.
-

FOSQUEANTE
É um aditivo que tem a finalidade de reduzir o brilho das peças.
-

MB FILLER
É um concentrado de carga mineral, aplicável em resinas termoplásticas como PE, PP, EVA, PS, podendo ser utilizado na maioria dos processos de transformação.





